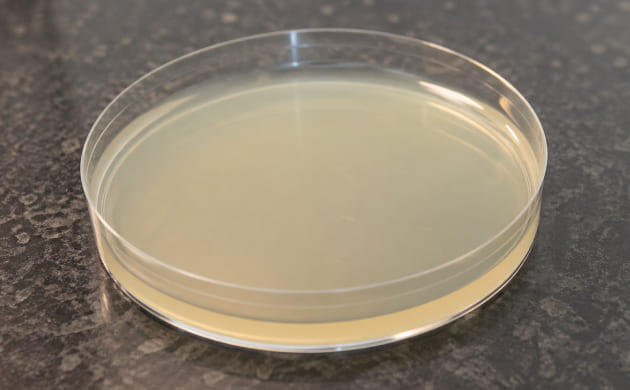
Пошаговое приготовление агаровой питательной среды

Микроклональное размножение – это получение генетически точных копий растения из микроскопического кусочка ткани. В качестве исходного материала берут верхушечные меристемы, которые помещают в стерильную питательную среду на основе агара. Метод позволяет воспроизвести полноценный куст конопли без классического черенкования, сохранив всё – генетику, урожайность, профиль каннабиноидов, аромат и другие сортовые особенности исходника. Именно это делает его незаменимым инструментом для тех, кто гонится за повторяемостью результата или хочет законсервировать идеальный фенотип. Наш материал про то, как это работает и как воспроизвести процесс дома. Для обсуждения этой темы приглашаем всех желающих на наш форум, там собираются гроверы и канна-энтузиасты со всех уголков страны.
В чем смысл использования тканевой культуры вместо обычных черенков?

Черенкование знакомо каждому гроверу, но у него есть потолок: количество клонов ограничено размером материнского куста, а чем дольше она в работе – тем выше риск накопленных скрытых инфекций, грибков и вирусов, которые передаются потомству незаметно.
Микроклональное размножение конопли работает иначе. Стартовый материал – микроскопический эксплант, работа ведётся в стерильной среде, что исключает патогены. Из одного фрагмента получают десятки и сотни идентичных клонов. А использование меристемы даёт бонус – возможность «перезапустить» генетику и очистить линию от накопленных инфекций, восстановив чистые клоны даже из проблемных кустов.
Для каннабиса это особенно ценно: метод позволяет зафиксировать стабильные экземпляры медицинских и высокоурожайных сортов, а редкие фенотипы размножать кратно быстрее, чем при классическом черенковании.
Реально ли организовать микроклональное размножение дома?

Практика показывает, что тканевая культура вполне реализуема вне лабораторий. Хороший ориентир – это сообщества грибников, где аналогичные принципы стерильной работы давно применяются в домашних условиях. По тому же сценарию можно собрать компактную мини-лабораторию для микроклонирования каннабиса. Базовый набор прост, но ключевые роли играют аккуратность, стерильность и внимание к деталям. DIY-сообщества, особенно в США и Канаде, накопили тысячи успешных кейсов выращивания каннабиса in vitro в домашних условиях. Энтузиасты получают десятки стабильных клонов, затрачивая минимум ресурсов и обходясь без промышленного оборудования.
Оборудование и инструменты для домашней культуры тканей

Для работы с эксплантами потребуется следующий минимум инструментов:
скальпель или острый нож – для точного отделения фрагментов ткани;
пинцет – для аккуратного переноса эксплантов между средами;
стеклянные банки объёмом 50-500 мл – выполняют роль импровизированных пробирок, подойдут ёмкости из-под детского питания или варенья;
перчатки и маска – помогают поддерживать стерильность рабочей зоны;
зажигалка или спиртовка – используется для обжига инструментов;
шприц или мерный стакан – для точного дозирования жидкостей;
ювелирные весы – необходимы при работе с малыми дозами компонентов;
pH-метр – позволяет контролировать кислотность питательной среды.
Компоненты для приготовления питательной среды

Основа успешного микроклонального размножения – это правильно собранная среда, куда входят:
агар-агар – формирует гелеобразную структуру, подходит обычный пищевой агар;
сахароза – источник энергии для тканей, допустим стандартный белый сахар;
сухая MS-среда (Murashige & Skoog) – сбалансированный набор минералов и витаминов;
BAP (бензиладенин) – цитокинин, стимулирующий деление клеток и формирование побегов;
NAA или IBA – ауксины, отвечающие за развитие корневой системы;
витамины группы B, особенно B1 и B6, – поддерживают рост и метаболизм, допускаются аптечные аналоги.
При соблюдении чистоты и точности даже домашние условия позволяют выстроить стабильный процесс микроклонального размножения конопли без серьёзных компромиссов по качеству.
Почему в агар нельзя просто добавить обычные удобрения?
При работе с тканевой культурой каннабиса логика питания меняется радикально. Среда in vitro – это не субстрат и не гидропоника, а полностью изолированная система, где каждый элемент выполняет строго определённую функцию. Именно поэтому привычные удобрения здесь не работают.
Роль сахара в культуре тканей

В условиях выращивания в пробирке ткани не способны полноценно фотосинтезировать, особенно на ранних стадиях развития. Свет присутствует, но энергетический обмен остаётся ограниченным. В такой ситуации внешний источник углеводов становится критически важным, так как:
сахар служит основным источником энергии для клеток;
без углеводов ткани либо не развиваются, либо постепенно деградируют;
минеральные удобрения не содержат сахаров и не могут заменить этот компонент.
В качестве временной альтернативы сахарозе иногда используют:
аптечную глюкозу;
продукты с декстрозой;
мёд, но с высокой осторожностью из-за риска заражения.
Оптимальным и самым стабильным вариантом остаётся обычный белый сахар в концентрации около 30 г на литр среды.
Почему без гормонов роста не обойтись?
BAP (бензиладенин) относится к группе цитокининов и играет ключевую роль в микроклональном размножении, так как:
стимулирует деление клеток;
запускает формирование побегов;
направляет развитие ткани в сторону вегетативного роста.
Стандартные удобрения, даже с полноценной формулой NPK, не содержат фитогормонов. В результате без BAP или его природных аналогов (кокосовой воды, экстрактов зелёного чая) культура часто уходит в образование каллуса – бесструктурной массы клеток без побегов.
Зачем нужна MS-среда?

MS-среда (Murashige & Skoog) – это базовый стандарт для выращивания растительных тканей in vitro. Она была разработана в 1962 году и до сих пор остаётся фундаментом микроклонального размножения. При выращивании каннабиса на агаре вся система питания должна быть встроена в среду, фактически заменяя почву и корневую зону. MS-среда решает эту задачу комплексно.
В её состав входят:
макроэлементы – азот, фосфор, калий, кальций, магний;
микроэлементы – железо, бор, цинк, медь, марганец и другие;
витамины – тиамин (B1), инозитол, никотиновая кислота;
хелат железа Fe-EDTA для стабильного усвоения;
иногда регуляторы роста, но чаще они добавляются отдельно.
MS-среда продаётся в виде сухого порошка, растворяется в дистиллированной воде, после чего в неё добавляют сахар и агар. Готовая смесь обязательно стерилизуется перед использованием.
Теоретически возможно собрать альтернативную рецептуру из отдельных солей и витаминов и обойтись без MS-среды. На практике это приводит к нестабильным результатам, проблемам с балансом элементов и потере повторяемости. Именно поэтому MS-среда остаётся самым надёжным и предсказуемым вариантом для домашней культуры тканей каннабиса.
Базовые условия для успешного микроклонального размножения конопли
Микроклональное размножение не требует сложного оборудования, но чувствительно к окружающей среде. Стабильность и чистота здесь важнее мощности ламп и лабораторного антуража.
Световой режим и микроклимат
Для нормального развития каннабиса требуется мягкое и стабильное освещение. В отличие от взрослых кустов ткани не нуждаются в интенсивном световом потоке, требуется:
продолжительность освещения около 16 часов в сутки с обязательной фазой покоя;
источник света с холодным спектром, близким к дневному, который вполне справляется с задачей;
умеренная мощность освещения без перегрева среды и банок;
стабильная температура в диапазоне 22-26 °C, обеспечивающая наиболее предсказуемый рост;
дополнительный контроль влажности обычно не требуется, так как культура находится в закрытом объёме.
Организация чистого рабочего пространства

Контаминация – это главный враг культуры тканей, поэтому зона для работы должна быть максимально изолированной от пыли и любых спор:
прозрачный контейнер с крышкой используется как простой аналог ламинарного бокса;
внутренняя поверхность перед каждой сессией тщательно обрабатывается антисептиком;
инструменты дезинфицируются непосредственно в процессе работы, а не заранее.
Дополнительные меры защиты от заражений
Даже мелкие детали способны повлиять на результат, поэтому вспомогательные средства играют важную роль:
спиртовые растворы применяются для обработки рук, поверхностей и инструментов;
открытое пламя помогает быстро стерилизовать металл и снижает количество микроорганизмов в рабочей зоне;
соблюдение последовательности действий и минимизация лишних движений значительно повышают шансы.
Приготовление питательной среды на основе агара

В микроклональном размножении конопли питательная среда играет роль полностью контролируемой экосистемы. Это не просто раствор, а искусственно собранная основа, которая заменяет корневую зону и почву, обеспечивая ткань всем необходимым для развития в условиях in vitro.
Такая среда выполняет сразу несколько функций:
служит источником влаги для клеток;
обеспечивает энергией за счёт легкоусвояемых углеводов;
поставляет макро- и микроэлементы в строго заданных пропорциях;
регулирует рост и направление развития с помощью фитогормонов;
фиксирует все компоненты в плотной структуре за счёт агара.
По сути, это «жидкая почва», переведённая в гелеобразное состояние и полностью очищенная от внешних факторов.
Базовый состав среды (на 1 литр)

Ниже приведён минимальный, но рабочий набор компонентов, подходящий для микроклонального размножения каннабиса:
дистиллированная вода – основа среды, без примесей и солей;
сахароза – около 30 г как основной энергетический субстрат;
агар-агар – 6-8 г для формирования стабильного геля;
сухая MS-среда – примерно 4,3 г при наличии доступа к стандартной формуле;
регуляторы роста, подбираемые в зависимости от задачи:
- BAP в концентрации 0,5-1 мг/л для стимуляции побегообразования;
- NAA или IBA в диапазоне 0,05-0,1 мг/л для закладки корневой системы;
кислотность среды корректируется до значения 5,7-5,8 перед стерилизацией.
Такой состав обеспечивает сбалансированное питание и предсказуемое развитие каннабиса на всех ранних этапах.
Упрощённая версия без MS-среды
При отсутствии готовой MS-смеси допускается экспериментальный вариант с заменой отдельных компонентов. Он уступает по стабильности, но позволяет понять сам принцип работы культуры тканей. В качестве альтернативы используют:
небольшое количество комплексного минерального удобрения, снижая дозировку до символической;
витамин B1 как базовую поддержку клеточного метаболизма;
следы морской соли для внесения микроэлементов.
Такой подход не даёт идеального баланса и требует аккуратности, но подходит для первых опытов и отработки техники работы с агаровой средой.
Пошаговая схема приготовления агаровой среды
Ниже приведён базовый алгоритм, который позволяет получить стабильную и чистую питательную среду для микроклонального размножения каннабиса. Последовательность действий здесь важнее скорости.
Шаг 1. Подготовка и смешивание компонентов
Процесс начинается с формирования жидкой основы, в которой все элементы должны быть равномерно распределены:
в ёмкость заливается около 800 мл дистиллированной воды;
сахар добавляется первым и полностью растворяется при перемешивании;
агар вводится следующим, смесь аккуратно нагревается до умеренной температуры для лучшего растворения;
после этого вносят сухую MS-среду либо выбранный заменитель;
регуляторы роста добавляются отдельно, с предварительным растворением, если они в порошковой форме;
объём доводится дистиллированной водой до одного литра;
кислотность проверяется и корректируется до оптимального диапазона.
На этом этапе важно не перегревать раствор, особенно после внесения гормонов.
Шаг 2. Распределение по ёмкостям
Готовая смесь разливается до стерилизации, пока она остаётся жидкой:
используются стеклянные банки или пробирки малого объёма;
каждая ёмкость заполняется частично, чтобы оставить место для давления и пара;
банки закрываются крышками либо защищаются фольгой.
Чистота посуды напрямую влияет на результат, поэтому все ёмкости должны быть предварительно вымыты и обезжирены.
Шаг 3. Стерилизация среды
Уничтожение микроорганизмов – это ключевой этап всей процедуры. Здесь допускается несколько подходов:
при наличии автоклава или скороварки проводится стерилизация под давлением в течение 15-20 минут;
при отсутствии оборудования используется водяная баня с длительным кипячением;
для повышения надёжности процедуру повторяют на следующий день, применяя дробную стерилизацию.
Этот этап позволяет избавиться не только от бактерий, но и от устойчивых спор.
Шаг 4. Остывание и хранение
После обработки среде необходимо спокойно стабилизироваться:
банки охлаждаются при комнатной температуре без перемещения;
по мере остывания, агар переходит в плотное гелеобразное состояние;
готовая среда хранится в холодильнике в герметично закрытом виде не более двух недель.
Практические рекомендации
Некоторые мелочи заметно повышают шансы на успех:
агар растворяется равномернее при умеренном нагреве без активного кипения;
гормоны добавляются в уже слегка остывшую среду;
работа проводится в маске и перчатках с обязательной стерилизацией инструментов;
параллельное приготовление сред с разными дозировками гормонов помогает подобрать оптимальную формулу.
Чёткое соблюдение этих шагов создаёт стабильную основу для дальнейшей работы с культурой тканей и минимизирует риск потери материала.
Подготовка и стерилизация экспланта

Эксплантом называют микроскопический фрагмент каннабиса, который помещается в питательную среду для запуска деления клеток, формирования побегов и последующего укоренения. Именно от качества и типа исходной ткани во многом зависит успех всей культуры. Для микроклонального размножения конопли в домашних условиях используют участки, в которых сосредоточены активные зоны роста:
верхушечные точки роста с апикальной меристемой;
молодые листья вместе с черешками;
узлы со спящими почками;
отдельные фрагменты стебля между узлами при аккуратной подготовке.
Важно понимать, что не каждая часть каннабиса способна к регенерации. Все ткани конопли условно делятся на два типа:
меристематические – состоят из недифференцированных клеток, которые активно делятся и формируют новые структуры;
постоянные – выполняют специализированные функции и утратили способность к делению.
Для микроклонального размножения интерес представляет исключительно первая группа. Апикальная и вставочная меристемы ценятся особенно высоко, так как содержат клетки с максимальным потенциалом регенерации, часто изначально чище с точки зрения патогенов, быстрее формируют каллус и побеги в агаровой среде. Постоянные ткани, напротив, практически не реагируют на условия in vitro и не используются для клонирования.
Выбор материнского куста
Исходный материал определяет всё дальнейшее развитие, поэтому к выбору материнского куста стоит подходить максимально строго. Наилучшие результаты дают растения в фазе активной вегетации, а не цветения. При отборе стоит убедиться, что:
отсутствуют признаки грибковых поражений, вредителей и вирусных инфекций;
ткани выглядят молодыми и интенсивно растущими;
нет следов светового стресса, химических ожогов или дефицитов;
верхушки развиты равномерно и не деформированы.
Чистый и здоровый эксплант значительно снижает риск заражения среды и повышает вероятность успешного запуска микроклонального размножения.
Инструменты и расходники для стерилизации экспланта

Перед началом работы важно собрать всё необходимое, чтобы не отвлекаться в процессе и не нарушать стерильность. Подготовка – это половина успеха в культуре тканей. Для успешной реализации в домашних условиях потребуются:
одноразовые перчатки, маска и антисептик для рук;
пинцет и скальпель, заранее очищенные и продезинфицированные;
несколько стаканов или небольших ёмкостей для растворов;
таймер или часы для контроля времени обработки;
стерильная вода, полученная кипячением и охлаждением;
чистые бумажные салфетки без ворса.
Пошаговая схема стерилизации экспланта

Ниже приведён адаптированный алгоритм, рассчитанный именно на домашние условия без лабораторного оборудования.
Этап 1. Первичная очистка
Работа начинается ещё до химической стерилизации:
аккуратно срезается небольшой участок ткани, например верхушка с минимальным фрагментом стебля;
эксплант промывается под проточной водой с мягким моющим средством в течение пары минут;
после этого материал тщательно ополаскивается чистой водой, чтобы удалить остатки загрязнений.
Этот шаг снижает количество поверхностной микрофлоры и облегчает дальнейшую обработку.
Этап 2. Обеззараживание растворами
Этап включает следующие шаги:
работать следует без спешки, но в чётком ритме, используя перчатки и чистую посуду;
эксплант погружается в слабый хлорсодержащий раствор с концентрацией около 5-10 %, приготовленный из одной части отбеливателя и девяти частей воды;
в раствор добавляется капля обычного средства для мытья посуды, чтобы снизить поверхностное натяжение и улучшить контакт жидкости с тканями;
время обработки выдерживается в пределах 8-12 минут, эксплант периодически аккуратно встряхивают;
в качестве альтернативы допускается использование 3 %-ной перекиси водорода с экспозицией 10-15 минут либо 70 %-го спирта не дольше 30 секунд с обязательным немедленным промыванием;
после антисептической обработки эксплант промывается три-четыре раза в стерильной или предварительно кипячёной и охлаждённой воде, каждый раз в свежей порции.
Этап 3. Финальная подрезка ткани
После стерилизации некоторые участки могут выглядеть повреждёнными, поэтому:
края экспланта аккуратно обновляются стерильным инструментом;
любые манипуляции выполняются только пинцетом или скальпелем;
прямой контакт с руками полностью исключается.
Цель этого шага – оставить только живую и перспективную ткань.
Этап 4. Перенос на питательную среду
Посев проводится максимально быстро и в чистых условиях:
ёмкость с застывшим агаром открывается в защищённой зоне;
эксплант размещается на поверхности среды и слегка фиксируется;
банка сразу закрывается и маркируется с указанием даты и сорта.
Чем меньше времени среда контактирует с воздухом, тем выше шанс сохранить её чистой.
Условия инкубации после посева
Для дальнейшего развития важно поддерживать стабильную среду:
освещение с длительностью светового дня около 16 часов;
температура в комфортном диапазоне 22-26 °C;
рассеянный свет без прямого солнечного воздействия.
Что можно увидеть в первые недели?
Результаты становятся заметны не сразу, но уже через одну-три недели появляются первые признаки:
формирование зелёных участков и зачатков побегов говорит об успешном старте;
образование каллуса считается допустимым промежуточным этапом;
появление плесени или мутного налёта означает заражение, такой экземпляр лучше сразу удалить.
На этом этапе становится понятно, был ли выбран правильный эксплант и соблюдена ли стерильность на всех шагах.
Укоренение побегов каннабиса in vitro

После переноса экспланта на агаровую среду формируется замкнутая микросистема, по сути, мини-биореактор. Внутри неё ткань постепенно выходит из состояния покоя, запускает деление клеток и начинает формировать каллус, зачатки побегов или корневые структуры. Скорость реакции зависит от состава среды, качества стерилизации и физиологического состояния исходного материала. Первые признаки активности обычно проявляются в течение 5-14 дней. Для стабильного развития после посева важно поддерживать стабильные условия, а именно:
световой режим с продолжительностью освещения около 16 часов и обязательной тёмной фазой;
спектр освещения в диапазоне нейтрального или холодного белого света;
температура, удерживаемая в комфортном диапазоне 22-26 °C;
высокая влажность, которая автоматически поддерживается внутри герметично закрытой ёмкости;
размещение без прямого солнечного воздействия, чтобы избежать перегрева и фотостресса.
При благоприятном сценарии эксплант сохраняет насыщенный зелёный цвет и не проявляет признаков некроза. Уже через неделю можно заметить уплотнение тканей, локальное набухание или появление светлых зон активного роста. Далее формируются миниатюрные побеги либо каллус, которые начинают постепенно увеличиваться в размерах и ориентироваться вверх или в стороны. Именно на этом этапе становится ясно, насколько удачно подобраны условия и гормональный состав среды.
Типичные проблемы культуры тканей и их причины
Даже при аккуратной работе возможны сбои. Большинство из них легко распознать по внешним признакам, таким как:
появление белого или зелёного налёта указывает на заражение среды. Как правило, причина кроется в недостаточной стерилизации экспланта или инструментов. Такие экземпляры не пытаются спасать и утилизируют, не вскрывая ёмкость;
потемнение ткани, размягчение или признаки гниения чаще всего связаны с химическим ожогом. Это результат слишком высокой концентрации отбеливателя, перекиси или превышения времени обработки. В дальнейшем корректируют протокол стерилизации;
отсутствие заметного развития в течение двух и более недель говорит о проблемах со средой. Возможны ошибки в pH, недостаток сахара или некорректная дозировка гормонов; в таком случае образец пересеивают на обновлённую среду.
Пересадка и разделение побегов

Когда на агаре формируется самостоятельный мини-побег длиной около одного-двух сантиметров, его переводят на следующий этап. Процедура включает:
аккуратное отделение побега от исходного экспланта стерильным инструментом;
перенос на специализированную среду, ориентированную на укоренение;
смену гормонального баланса в сторону ауксинов.
Используются две базовые схемы:
для активного образования побегов – среда с BAP в концентрации 0,5-1,0 мг/л без добавления ауксинов;
для формирования корней – среда с IBA или NAA в диапазоне 0,1-0,5 мг/л без цитокининов.
На практике побеги сначала развиваются на цитокининовой среде, а затем их переносят на укореняющую.
Развитие корневой системы in vitro

После переноса побегов на ауксиновую среду отклик конопли обычно не заставляет себя ждать. Уже в течение первой или второй недели появляются тонкие светлые корешки, которые постепенно удлиняются и начинают ветвиться. Когда корневая система достигает длины примерно одного-двух сантиметров, культуру можно считать готовой к следующему этапу – переносу в субстрат. Перед этим переходом важно заранее подготовить клон к условиям вне стерильной среды, чтобы снизить стресс и повысить выживаемость.
А вот переход от агаровой среды к обычному субстрату – это самый чувствительный момент во всём процессе. Последовательность действий выглядит так:
укоренённый побег извлекается из ёмкости стерильным пинцетом;
корни тщательно промываются в кипячёной охлаждённой воде для удаления остатков агара;
растение высаживается в лёгкую воздухопроницаемую смесь, например в кокос с перлитом в равных пропорциях;
создаётся временный парниковый эффект с помощью прозрачного укрытия;
вентиляцию увеличивают постепенно, начиная с коротких интервалов.
Через несколько дней адаптации к обычному воздуху клон переходит к стандартному вегетативному развитию и дальше выращивается как полноценный экземпляр.
Проблемы, решения и полезные приёмы

Большинство неудач в тканевой культуре — не проблема технологии, а нарушение базовой логики процесса. Вот главные из них:
Заражение среды. Плесень, бактериальный налёт или муть — следствие слабой стерилизации экспланта, грязных инструментов или плохо приготовленной среды. Заражённую банку не лечат и не открывают — герметично упаковывают и утилизируют, затем ищут источник проблемы в рабочем процессе.
Гибель ткани после стерилизации. Если эксплант быстро темнеет и размягчается — это химический ожог. Причина в слишком высокой концентрации отбеливателя или перекиси, либо в превышении времени обработки. Решение — корректировка протокола стерилизации.
Отсутствие роста. Если эксплант выглядит живым, но две-три недели не даёт активности — проблема в составе среды, pH или отсутствии гормонов. Каллус без побегов указывает на гормональный перекос: избыток ауксинов при дефиците цитокининов.
Вот несколько приёмов, которые реально работают:
даже импровизированный бокс из пластикового контейнера защищает от пыли и воздушных потоков;
прокаливание пинцета и скальпеля между манипуляциями резко снижает риск заражения;
пищевая фольга заменяет стерильные крышки;
маркировка банок с датой и составом среды помогает понять, какие формулы дают результат.
Сорта-чемпионы конопли

- Фотопериодные
- 22.4 %
- Эйфория и радость
- Индор: 550 г/м² Аутдор: 1000 г/куст
Delicious Candy Early Version – это сорт с подтверждённым чемпионским статусом, который ценят не только за скорость и стабильность, но и за признание на профильных конкурсах. Его качества были неоднократно отмечены профессиональным жюри: 2-е место в номинации «Лучший индор» на Copa Asociación MF 2014, 3-е место на Copa Asociaciones de Cannaval 2015 в категории Premio, а также 3-е место в номинации «Лучший индор» на Secret Cup 2017. Такой послужной список говорит сам за себя и подчёркивает высокий класс этого гибрида. Генетически сорт представляет собой ускоренную версию Delicious Candy с выраженным уклоном в индику. В основе лежит союз легендарного Cheese и фирменного Caramelo. Такое сочетание обеспечило высокую урожайность, устойчивость к плесени и рекордно короткий период цветения, который составляет всего около 45 дней. Сорт формирует ветвистые, хорошо раскрытые кусты с большим количеством боковых побегов. Соцветия плотные, обильно покрытые крупными трихомами. Аромат и вкус узнаваемые и насыщенные, яркий сырный профиль переплетается с нотами карамели и лакрицы. При уровне ТГК около 22,4 % эффект начинается с приподнятой эйфории и лёгкой ясности, после чего плавно переходит в мягкий телесный релакс.

- Автоцветущие
- 21 %
- Сбалансированное воздействие
- Индор: 450 - 600 г/м² Аутдор: 50 - 250 г/куст
West Coast O.G. Auto – это автоцветущий индика-доминантный гибрид с по-настоящему чемпионским происхождением. Его уровень проработки был официально подтверждён победой на конкурсе Copa Cannábica Litoral de los Poetas, где сорт занял 1-е место. West Coast O.G. Auto вырастает компактным, надёжным и универсальным. Кусты редко превышают 60-100 см в индоре и достигают около метра в аутдоре, полный жизненный цикл занимает 9-10 недель. Урожайность доходит до 450-600 г/м² в помещении и до 250 г с растения под открытым небом при благоприятных условиях. Уровень ТГК составляет около 21 %, КБД – до 1 %, что усиливает медицинский потенциал сорта. Эффект развивается быстро, сначала глубокий телесный релакс с выраженным антистрессовым действием, затем мягкий эмоциональный подъём. Аромат классический, кушевый: цитрусы, хвоя и смолистая свежесть.

- Фотопериодные
- 22 %
- Сативный high, с ментоловыми оттенком
- Индор: 500 г/м² Аутдор: 500 - 1500 г/куст
Nefertiti – это сорт с по-настоящему царственным происхождением и чемпионским статусом. Высокий уровень селекции был официально признан в 2007 году, когда Nefertiti заняла 1-е место в категории Indoor Hydro Cup на Spannabis Cup. Генетически Nefertiti является сатива-доминантным гибридом, но на ранних стадиях роста могут проявляться изящные, почти индичные листья. В индоре растения обычно достигают около 100 см, но при активной веге способны вырастать значительно выше. Цветение занимает 10-12 недель, а урожайность при хорошем освещении превышает 500 г/м². В аутдоре потенциал раскрывается ещё ярче, в плодородной почве и тёплом климате урожайность доходит до 500-1500 г с одного растения. Аромат у Nefertiti тонкий и благородный, с нотами лимона, клубники и апельсиновой цедры, иногда с лёгким ментоловым оттенком. При содержании ТГК до 22 % эффект мощный, яркий и продолжительный.

- Фотопериодные
- 26 %
- Бронебойная эйфория и чистый разум
- Индор: 550 - 650 г/м² Аутдор: 1000 г/куст
Pineapple Chunk – это сорт с чемпионским характером, который сумел выделиться даже среди титулованных индика-доминантных гибридов. Его уровень был официально подтверждён в 2009 году, когда этот стрейн стал призёром Indica Cup. В культивации сорт показывает себя как компактный, устойчивый и щедрый гибрид. Кусты редко превышают 90-110 см. Урожайность доходит до 650 г/м² в помещении и до 1 кг с куста на улице. Цветение занимает 55-60 дней, растения обладают крепким иммунитетом и хорошо реагируют на подкормки. Аромат и вкус стали ещё одной причиной признания сорта на кубке, сладкий ананас здесь переплетается с насыщенными сырными и пряными оттенками. Несмотря на преобладание индики, Pineapple Chunk удивляет нетипичным для такого профиля эффектом: вместо тяжёлого стоуна здесь доминирует чистый приподнимающий эйфорический хай. При уровне ТГК до 25 % и содержании КБД около 1,1 % сорт демонстрирует выраженные терапевтические свойства, помогая справляться со стрессами, болями и мигренями.

- Фотопериодные
- 30 %
- Мотивирующий high-stone
- Индор: 400 - 450 г/м² Аутдор: 450 - 550 г/куст
Jealousy – индика-доминантный гибрид с генетикой Sherbert Bx1 x Gelato 41, признанный сортом года по версии Leafly в 2022-м и занявший второе место на California High Times Cannabis Cup. Оба родителя несут преимущественно индичную кровь и сильные терапевтические качества, которые в полной мере перешли к потомку. Кусты вырастают до 150 см, цветут 56-70 дней и в индоре отдают 400-450 г/м², на открытом воздухе – до 550 г с куста. Гибрид одинаково комфортно чувствует себя в почве и на гидропонике. Терпеновый профиль строится на кариофиллене, лимонене и мирцене: аромат ореховый и обволакивающий, вкус неожиданно острый с перечной подписью, которая запоминается с первого раза. ТГК 30% действует плотно и многогранно: почти сразу приходит волна мотивирующего подъёма, сознание наполняется ясностью и лёгкой эйфорией, а следом тело уходит в глубокое расслабление без ощущения отключки. Этот high-stone одинаково хорош и для творческого импульса, и для вечернего сброса напряжения, а терапевтический потенциал делает его востребованным среди тех, кто ищет помощи при хронической боли и бессоннице.
*Вся представленная информация носит исключительно ознакомительный характер и не является руководством или призывом к действию.
**Напоминаем, что использование семян марихуаны в качестве посевного материала (выращивание конопли с целью получения растения) запрещено УК Российской Федерации. Подробнее с законом Вы можете ознакомиться здесь.







Все комментарии проходят модерацию. Правила для публикаций:
Общие вопросы, не относящиеся к статье, также будут удалены.